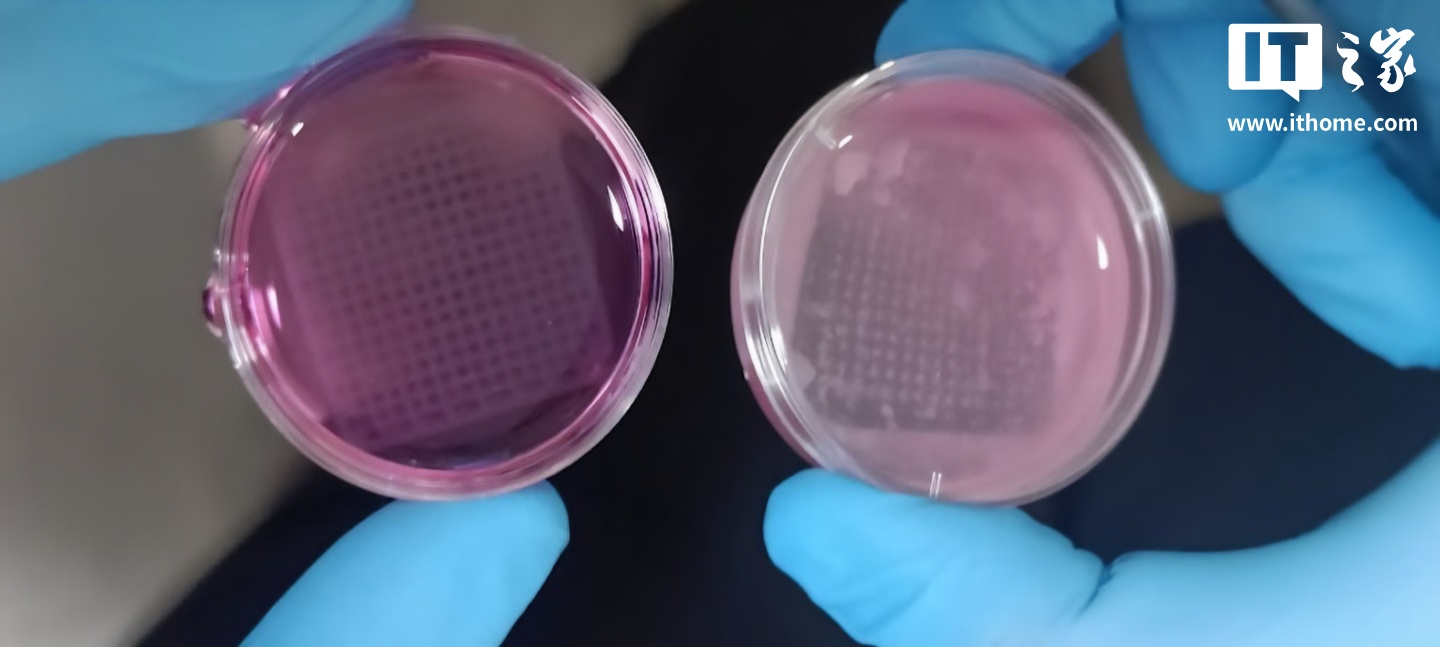

IT之家 4 月 6 日消息,在欧盟 2010/63 号指令对化妆品及成分的动物实验施加严格限制后,一支国际科学家团队开发出了一种逼真的、3D 打印的带有活细胞的皮肤模型,为安全测试化妆品及其纳米颗粒提供了一个可靠且符合伦理道德的平台。

据IT之家了解,该 3D 打印皮肤模型能够高度模拟人类皮肤的三层组织结构和功能,研究人员利用水凝胶配方与活细胞一同打印,从而实现对化妆品纳米颗粒的准确且符合伦理的检测。水凝胶作为介质,在其中扮演着至关重要的角色。格拉茨技术大学化学与生物基系统技术研究所的卡琳・斯坦纳・克莱因谢克教授(Karin Stana Kleinschek)表示,用于皮肤仿真的水凝胶必须满足多项要求,包括能够与活皮肤细胞相互作用,使细胞不仅能存活,还能生长和繁殖。
然而,水凝胶的高含水量虽然为细胞整合和生长创造了理想条件,但也导致其结构不稳定。为此,奥地利的研究人员正在努力通过特殊的机械和化学方法对其进行交联,以实现稳定化,且整个过程需在非常温和的条件下进行,避免使用细胞毒性化学品。一旦成功稳定,团队便会在细胞培养中测试 3D 打印皮肤模型的耐用性和潜在毒性。
只有当嵌入水凝胶中的皮肤细胞在细胞培养中存活两到三周并开始形成真正的皮肤组织时,该结构才能被视为真正的皮肤仿制品,进而用于化妆品产品的进一步细胞检测。据克莱因谢克教授介绍,初步的细胞培养测试结果令人鼓舞,表明交联后的材料既具有机械稳定性,又对细胞无毒性。
接下来,研究人员将利用 3D 打印模型对纳米颗粒进行测试。克莱因谢克教授强调,这是 TU Graz 和 VIT 互补研究的成功。她表示:“我们在组织仿真材料研究方面的多年经验与 VIT 在分子和细胞生物学方面的专业知识完美结合。我们目前正在合作进一步优化水凝胶配方,并验证其作为动物实验替代品的实用性。”
该研究已在《STAR Protocols》期刊上发表。

“掌”握科技鲜闻 (微信搜索techsina或扫描左侧二维码关注)

















